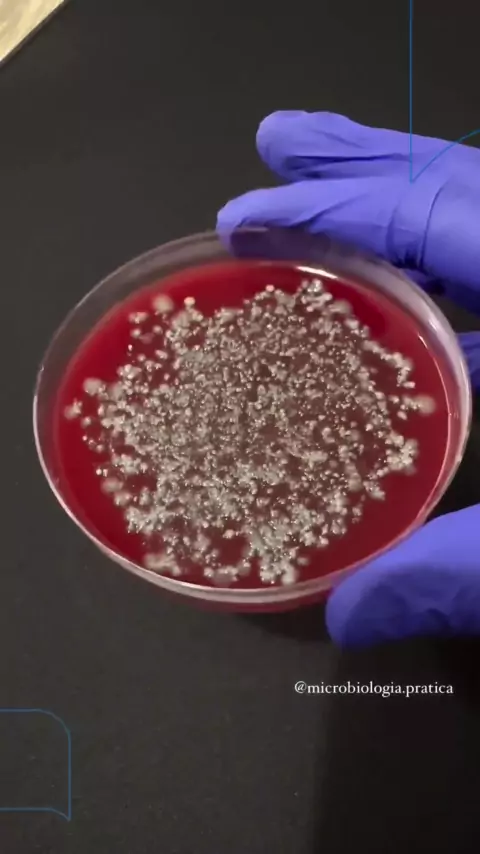

Follow
15
0
Portal R7
O professor e consultor em microbiologia, Bruno Brunetti, mostrou como os microorganismos se desenvolvem em um meio de cultura.
More
Comment
Cancel
Send

Follow
1.5K
14
Famosos da Internet
#MundoDosFamosos #fofocadosfamosos #entretenimento #Celebridade #EstrelaDeFamília
More

Follow
2.8K
164
MÃE DO MLK SONHADOR
Deus cura fé
More